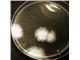
محیط های کشت آزمایشگاهی مرک آلمان - لیو ایتالیا

پلاریمتر . رفرکتومتر آتاگو ژاپن
فروش انواع پلاریمتر و رفرکتومتر ژاپنی و تایوانی رفرکتومتر چشمی و رفرکتومتر دیجیتال رومیزی - پلاریمتر . رفرکتومتر آتاگو ژاپن - پلاریمتر . رفرکتومتر آتاگو ژاپن پلاریمتر تایوانی و ژاپنی آتاگو 09125035538
قیمت
اطلاعات تامین کننده
رایان شیمی پارس
تهرانتولید کننده، وارد کننده، عمده فروش، خرده فروش، صادر کننده، خدمات
آون -شیکر - میکسر آزمایشگاهی ، انکوباتور ساده و یخچالدار، بن ماری آب و روغن ، هود شیمیائی و میکروبی ، سکوبندی آزمایشگاهی ، میکروسکوپ ساده و پلاریزان دو چشمیو سه چشمی ، ترازو و رطوبت سنج ، مواد شیمیائی مرک آلمان، محیط های کشت میکروبی مرک و کیو لب ، شیشه آلات آزمایشگاهی ، کجلدال و سوکسوله، میز ترازو
مشاهده سایت فروشندهخرید از تامین کنندگان برتر پارس سنتر!

تامین کنندگان برتر پارس سنتر سرعت پاسخگویی بالاتر و محصولات بروز تری نسبت به سایر تامین کنندگان دارند.
مشخصات
- کشور سازنده
- ژاپن
- رفرکتومتر
- پلاریمتر
توضیحات محصول
فروش پلاریمتر آتاگو و دستی - انوا رفرکتومتر چشمی - رفرکتومتر دیجیتال - رفرکتومتر رو میزی
** واردات و فروش انواع پلاریمتر Polarimeter از برترین کمپانی های سازنده از جمله کمپانی آتاگو ژاپن و پلاریمتر دستی از تایوان **
فروش انواع پلاریمتر و رفرکتومتر ژاپنی و تایوانی رفرکتومتر چشمی و رفرکتومتر دیجیتال رومیزی - پلاریمتر . رفرکتومتر آتاگو ژاپن
پلاریمتر تایوانی و ژاپنی آتاگو 09125035538
از مشخصات و کاربردهای این محصول :
• پلاریمتر وسیله ای بسیار حساس و دقیق بوده و جهت استفاده در کارخانه های تولید شکر، نشاسته ، آبمیوه همچنین فراورده های لبنی بسیار مناسب می باشد .
• کاربرد در کارخانه های داروسازی و مراکز کنترل مواد دارویی و مواد مخدر
• کاربرد در صنایع مکمل سازی و داروسازی جهت تولید اسید آمینه – گلوکز و فروکتوز
• جهت اندازه گیری درصد خلوص موادی مانند کودئین – نیکوتین – اسید آسکوربیک – کافور – آلبومین – نعناع
• قابل استفاده در آزمایشگاه های سم شناسی ، هورمون شناسی و همچنین کاربرد در پژوهش های شیمی
• پلاریمتر با توجه به فیلترهای پلاریزه خود عمل می نماید . به این ترتیب که نور پلاریزه از نمونه مورد آزمایش و از فیلتر پلاریزه دوم عبور کرده و به وسیله سنسور حساس اندازه گیری می گردد . زاویه چرخش فیلتر دوم در واقع بیانگر زاویه چرخش نور توسط نمونه مورد آزمایش است .
** توجه نمایید پلاریمتر تایوانی با فیلتر و لامپ اضافی موجود می باشد **
این محصول با بهترین کیفیت و مناسب ترین قیمت به فروش می رسد .
021-22144680-3
از شما که در تمام این سالها در کنار ما بوده اید سپاسگذاریم
در شبکه های اجتماعی همراه ما باشید
https://www.instagram.com/rspgroupco/
https://t.me/Rayanshimipars
09125035538
فروش انواع پلاریمتر و رفرکتومتر ژاپنی و تایوانی رفرکتومتر چشمی و رفرکتومتر دیجیتال رومیزی - پلاریمتر . رفرکتومتر آتاگو ژاپن - پلاریمتر . رفرکتومتر آتاگو ژاپن
پلاریمتر تایوانی و ژاپنی آتاگو